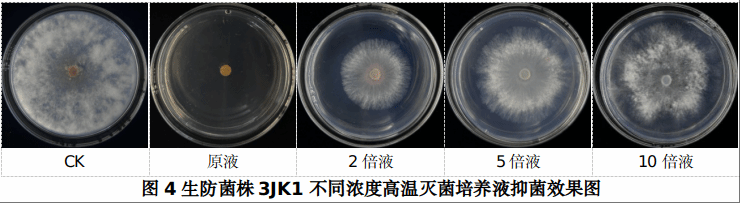

由植物科学学院臧建成教授主持的西藏自治区科学技术厅2023年度自治区重点科技计划项目“拉萨南北山生态林病虫害生态调控机理与应用技术研发”,自2023年3月启动以来,聚焦拉萨南北山造林区面临的杨树腐烂病、砂生槐虫害等突出难题,成功构建了从精准监测到集成示范的全链条绿色防控体系,为重大生态工程的长效管护提供了关键支撑。


项目核心成效在于构建了一套“摸清家底—靶向攻关—集成示范”的生态林病虫害防控体系。不仅首次系统构建了造林区病虫害数据库,更在关键技术上取得双重突破:一是成功筛选出对杨柳树腐烂病抑制率达100%的高效生防菌株3JK1,二是首次鉴定出关键固沙树种砂生槐食叶性害虫苦参野螟。项目将上述核心成果集成为一套可推广的生态防控技术模式,并在宝瓶山建成200亩防治示范区,为拉萨南北山绿化工程提供了从“被动救治”转向“主动防控”的完整解决方案。

本项目的实施,为拉萨南北山绿化工程提供了关键技术支撑,探索出一套高海拔生态林病虫害绿色防控的有效方案,为区域生态屏障的建设、管护提供了可复制的实践经验。
文:次仁曲珍
图:臧建成
审校:江洋、王志远